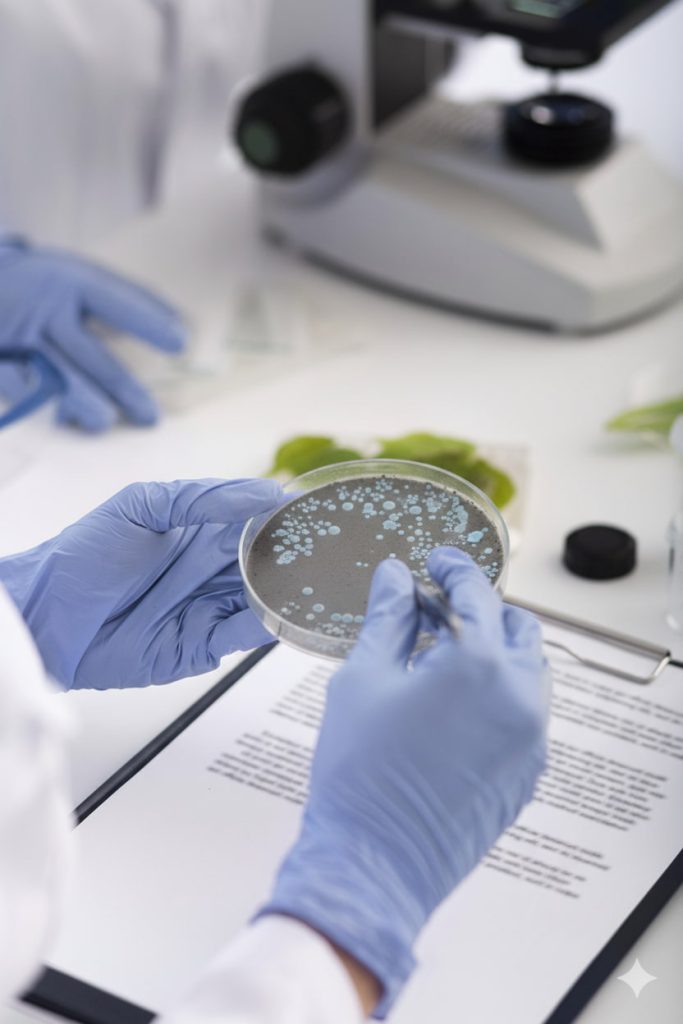
formación y capacitación de personal

Control y prevención de la legionella
Empresa especializada encumplimiento normativo, prevención y gestión técnica de riesgos por Legionella en instalaciones de agua en Barcelona, Tarragona y Lérida .
RD 487/2022
Control sanitario integral conforme al RD 487/2022
En Quiprocalt somos especialistas en el control y la prevención de la Legionella, garantizando el cumplimiento del Real Decreto 487/2022 y asegurando la protección sanitaria de todo tipo de instalaciones: torres de refrigeración, condensadores evaporativos, ACS, depósitos, spas, jacuzzis, fuentes ornamentales y más.
Nuestro servicio combina diagnóstico técnico, análisis de laboratorio, limpieza y desinfección, mantenimiento periódico, formación y asesoramiento normativo, con un enfoque 100% profesional y orientado a eliminar riesgos de proliferación de Legionella.

Nuestro proceso
PASOS QUE SEGUIMOS EN EL TRATAMIENTO Y PREVENCION DE LA LEGIONELLA

1. Diagnóstico y evaluación inicial
Inspección técnica completa y análisis microbiológico
Realizamos una evaluación detallada para identificar riesgos, incumplimientos normativos y factores que puedan favorecer la proliferación de Legionella.
Incluye:
- Inspección técnica de todas las instalaciones susceptibles.
- Toma de muestras de agua y superficies.
- Análisis microbiológicos para detección de Legionella spp.
- Medición de parámetros físico-químicos: temperatura, pH, cloro residual, conductividad, biocidas, etc.
- Evaluación de riesgo conforme al RD 487/2022 u otras normativas aplicables.
- Informe técnico completo con resultados, diagnóstico y recomendaciones.
Este diagnóstico es la base para establecer un plan de prevención eficaz.

2. Plan de prevención y control de Legionella (PPCL / PSL)
Diseño personalizado adaptado a cada instalación
Elaboramos un plan sanitario ajustado a las particularidades de cada sistema y a los requisitos normativos.
El PPCL/PSL incluye:
- Identificación de puntos críticos (zonas de estancamiento, temperaturas favorables, presencia de biocapa, etc.).
- Definición de medidas preventivas específicas.
- Programación de limpiezas y desinfecciones.
- Planificación de controles analíticos y verificaciones operativas.
- Registros y documentación obligatoria para auditorías e inspecciones sanitarias.
Nuestro enfoque permite garantizar control continuo, trazabilidad y cumplimiento legal.

3. Limpieza y desinfección de instalaciones
Eliminación de incrustaciones y agentes patógenos
Aplicamos técnicas avanzadas para asegurar una desinfección efectiva y documentada.
Realizamos:
- Limpieza física de tanques, depósitos, conducciones y equipos.
- Desinfección química: cloración, peróxidos, biocidas autorizados.
- Desinfección térmica (choque térmico).
- Eliminación de incrustaciones y biocapa (biofilm).
- Gestión y retirada de residuos generados.
- Emisión del certificado de desinfección según normativa.
Estas actuaciones reducen drásticamente el riesgo de proliferación bacteriana.

4. Control y mantenimiento periódico
Monitorización constante para evitar riesgos y desviaciones
Establecemos un sistema de control continuo para asegurar que la instalación se mantiene en condiciones seguras.
Incluye:
- Monitorización de parámetros físico-químicos.
- Revisión y calibración de equipos de dosificación y control.
- Muestreos periódicos para detección de Legionella.
- Registro documental de todas las actuaciones.
- Auditorías internas y actualización del PPCL/PSL según nuevas exigencias.
Un mantenimiento continuo reduce incidencias y evita sanciones.
Formación obligatoria y actualizada
Formación y capacitación del personal
Ofrecemos formación específica para personal de mantenimiento y responsables técnicos.
Formamos en:
- Procedimientos de prevención y control.
- Buenas prácticas operativas.
- Requisitos del RD 487/2022 y actualizaciones normativas.
- Identificación de riesgos y actuación ante incidencias.
La formación adecuada es clave para un control eficaz.
Soporte para cumplir con todas las exigencias legales
Asesoramiento técnico y normativo
Acompañamos a las empresas en todo el proceso de adecuación normativa.
Ofrecemos:
- Adaptación de instalaciones a la normativa vigente.
- Asesoramiento en diseño higiénico para nuevas instalaciones.
- Acompañamiento en inspecciones sanitarias.
- Optimización de procesos para reducir riesgos y costes.
Somos tu apoyo técnico ante cualquier requerimiento sanitario.
Solicita tu tratamiento de legionella
Si necesitas una empresa especializada en control y prevención de legionella, en Quiprocalt podemos ayudarte.
